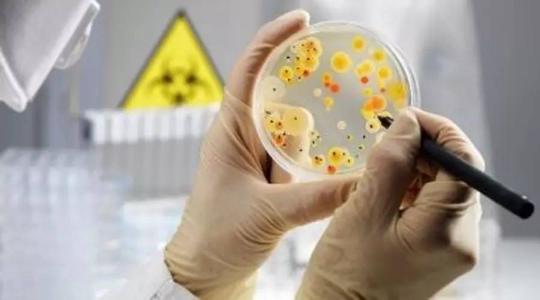

地址:河北省邯郸市永年区西苏镇北李固村村东
电话:15231866781
传真:0536-8889800
电话:15231866781
传真:0536-8889800
当前所在位置:网站首页 ->微生物检测
 微生物检测
微生物检测
微生物检测
添加时间:2015-8-12 | 文章录入:本站 | 文章来源:原创
微生物检测是食品检测的重要项目,餐饮业、加工食品的微生物指标都需要达到标准,否则将危害人类健康。检验的目的,一是监测生产过程中是否有严重偏差(如半成品受到污染),以便及时纠正和召回产品;二是积累数据并定期分析,并根据分析结果来监测生产过程、工艺、产品质量等是否出现波动、偏差和漂移,以便纠正和调整。
金年会app手机版在线登录经过严格考核评审,具有CNAS和CMA相关资质,并且微生物实验室布局合理,洁净度高,可以对非致病菌进行检测,同时还可在P2实验室内进行食源性致病菌的检测,保证产品质量安全。
微生物检测
